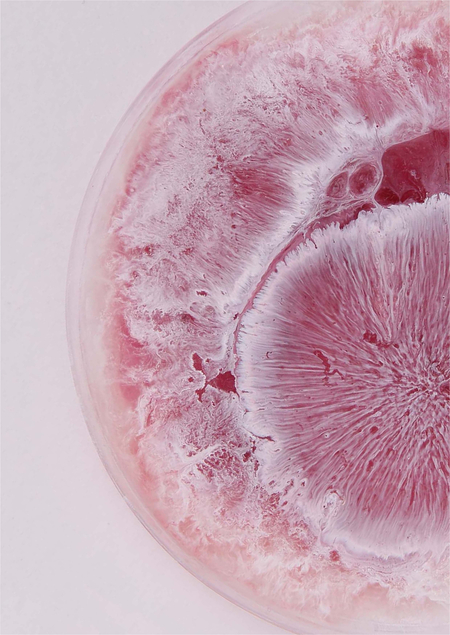

Текстом для моих иллюстраций выступают химические формулы веществ, с которыми человек сталкивается в обычной жизни. Этим я хочу показать: красота находится не только вокруг нас, но и внутри этих окружающих вещей.

KMnO₄

Работы выполнены в чашках Петри из эпоксидной смолы. Так создается впечатление, что перед нами — настоящее химическое вещество.

C₂₀H₁₂O₅
C₄₃H₅₈N₄O₁₂
TiO₂
C₂₂H₂₀O₁₃
CuCl₂
CuSO₄
Cu (OH)₂
Cu₂CO₃
C₅₅H₂₂O₅N₄Mg
KMnO₄
K₂Cr₂O₇